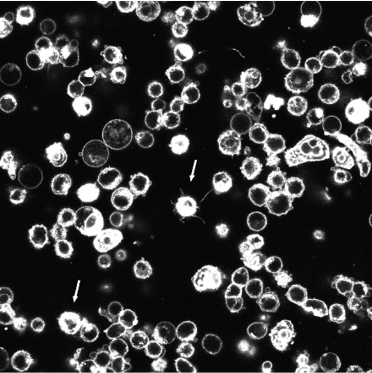

University of Maryland Greenebaum Comprehensive Cancer Center
Department of Pharmacology and Physiology
What are microtentacles? What is mechanotransduction? The newly discovered…
Our most recent publications, presentations, and abstracts.
Meet the crew! Learn about our individual research projects, education, and hobbies.
 The S.S. Martin Lab goes sailing!
The S.S. Martin Lab goes sailing!
About Us
Visit our University of Maryland School of Medicine web page
More About Us



